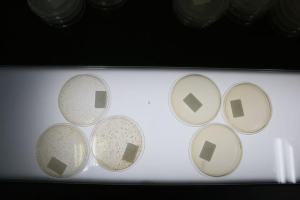

臭氧发生器工作原理
臭氧发生器工作原理
臭氧发生器工作原理

—————— 质量公开课028期 ——————
突如其来的疫情,让大众无时不刻进行各种“消毒”。市面上消毒用品的需求也呈现出爆发式增长。无论是酒精、消毒水、免洗洗手液等个人消毒用品,还是空气净化器、紫外线消毒灯等消毒杀菌家电,都销量惊人。
近日,随着五一小长假外出需求的增长,一款网红新品消毒包也开始在宝妈群里疯传。一个跟化妆包大小的消毒包,只需3分钟,就能把孩子用的奶瓶、衣物、玩具甚至口罩进行消毒,延长口罩使用时间,并且宣称细菌杀灭率高达99.9%,这是真的吗?这种黑科技是否靠谱?最新一期质量公开课,南都鉴定评测实验室“质量公开课”同SGS专家一起揭秘这款“灭菌神器”。
扫码看直播 ↓

网页宣称“只要放得下都能进行消毒”
根据《新型冠状病毒感染的肺炎诊疗方案(试行第七版)》,新冠病毒对紫外线和热敏感。疫情发生以来,针对消毒、健康需求的各类网红产品也如雨后春笋冒了出来。
紫外线消毒包,就是其中一种。该类产品均价在两百至一千元不等,根据电商平台网页宣称,“只要放得下都能进行消毒”。无论是奶瓶奶嘴等婴儿用品、还是女性贴身衣物、手机、钥匙,甚至是外出戴的口罩,都可以放进消毒包进行消毒。

电商平台上相关消毒包产品
该类产品的构造都很相似,主要包括容器、紫外线发生器、控制电路。容器主要装承物品和防止紫外线泄漏,其内部都有反射光线材质,保证里面的物品都能被紫外线照射到。
紫外线发生器产生紫外线,一般分为LED和紫外灯管两种。紫外灯管对冠状病毒有效但产生臭氧,紫外灯对皮肤有害,且为非可见光,所以物品里会添加蓝光以提示消费者。控制电路可以控制消毒时间和开盖检测。

SGS电子电气实验室安规技术经理叶汉翔介绍,这类产品在早几年就已兴起,当时主要用于奶瓶等产品消毒,但由于产品认知度低等原因没有流行起来。本次新冠疫情爆发后,这类消毒产品需求增大,同时其具有消毒时间短、操作便携等优点,适合现代快节奏的生活。
【有效性测试】
细菌杀灭率大于99.99%
根据电商平台网页宣称,紫外线消毒包的细菌杀灭率高达99.9%。这种产品真能有效杀灭细菌? SGS农产食品实验室高级技术工程师丘燕对该产品进行了杀菌有效性测试,以此验证消毒包的杀菌功效。她选定大肠杆菌和金黄色葡萄球菌作为细菌样本,这两种细菌分别是革兰氏阴性菌和阳性菌的代表,都是常见的食源性致病微生物。


工程师对消毒包进行杀菌有效性测试
本次实验设置对照组和实验组,通过结果比对得出细菌杀灭率。在消毒包里放入带有一定浓度大肠杆菌和金黄色葡萄球菌的玻片,待消毒包运作完毕后,取出玻片,经过洗脱、稀释、倒入培养基等步骤,经48小时恒温培养后进行计数。
左:未消毒的参照组 右:经过消毒包消毒的实验组

实验结果表明,该款紫外线消毒包对这两种细菌的杀灭对数值均大于3.00(杀灭率大于99.99%),说明是能达到一定的杀菌效果的。
据悉,紫外线是阳光中波长100~400纳米的光线,分为UVA、UVB、UVC、UVD,真正具有杀菌作用的是UVC紫外线。其杀菌原理是通过紫外线的照射,破坏及改变微生物的DNA(脱氧核糖核酸)或RNA(核糖核酸)的分子结构,造成生长性细胞死亡和(或)再生细胞死亡,达到杀菌消毒的效果。
【安全性测试】
光照度泄露值在安全范围内
紫外线在消毒杀菌时,也存在安全隐患。叶汉翔介绍,由于紫外线对生物细胞的破坏作用,在使用紫外线杀菌灯时要注意不要直接照射到人体皮肤,更不能直接用眼睛去直视灯管。

“特别需要提醒的是,紫外线属于非可见光。也就是说,肉眼是看不到的,我们能看到的只是消毒灯的可见光分量。当我们感觉到灼伤的时候,人体已经受到了严重的伤害。”
南都记者发现,因为有些消毒包带有透视窗,可以随时看到消毒灯;部分消毒包样品拉链未到位或盖子未关闭时明显有蓝光泄露出来。这些紫外线会否对人体产生伤害?


工程师对消毒包进行紫外光线泄露测试
在光生物安全实验室,工程师对泄露的光线进行安全性测试。实验结果表明,两款样品的紫外线强度属于“无危险类”,即光照度泄露值在安全范围内。并且紫外线波长集中在253纳米。研究发现,足够强度的253纳米波长紫外线,照射30秒~1分钟可以杀死冠状病毒。

测试发现,消毒包的光照度泄露值在安全范围内,且波长对冠状病毒有杀灭效果。
消毒包会不会漏电?叶汉翔介绍道,“像插电的消毒箱220V供电有漏电危险,为此这类产品内壁增加金属壳体,防止紫外线照射塑料部分,避免造成壳体塑料老化产生漏电风险。而消毒包5V供电低压,漏电造成影响较小,则不用金属内壳保护。”

220V供电的消毒箱内壁应增加金属壳体,防止塑料老化


5V供电低压消毒包则不用金属内壳保护
【消毒原理】
紫外线会伤害皮肤和眼睛
疫情期间为满足大众需求,各类消毒新品纷纷面市、让人眼花缭乱。据悉,市面上常见家电杀菌类产品的杀菌原理主要包括三种:高温消毒、紫外线消毒、负离子/臭氧消毒。这些消毒原理各有优缺点,适用对象和场景也各不相同。

奶瓶消毒器、辐射式消毒碗柜等基本采用高温蒸汽消毒方式,用超过100℃的高温灭活细菌,是一种可靠的消毒方式。但是必须在密封环境下才能完成,而且可能破坏产品的防水层,温度太高容易损坏产品或出现烫伤事故。
紫外线杀毒利用UVC波段杀菌效果最好,且不需要密闭空间,保证照射到即可。缺点是穿透力低,堆叠的物体消毒效果差,且直接照射对皮肤和眼睛都有伤害,防护不到位,伤害人体时是没有感觉的,长期照射还会导致塑料老化。
臭氧/负离子消毒是空气放电产生的电子被氧原子O2捕捉,产生空气负离子O3,也就是臭氧。优点很明显,气体易扩散、功耗低,发生器体积小。缺点是气体容易泄露,伤害甚至刺激呼吸道并引起头昏。典型产品包括空气净化器。
【对象】
塑料、硅胶、堆叠物品
不建议用紫外线消毒包
根据消毒包的消毒原理,在消毒对象的材质选择上,有哪些注意的点?叶汉翔介绍,塑料、硅胶对紫外线敏感,长期照射易老化、变硬,因此这类材质产品不建议长期使用消毒包,高温消毒是比较好的消毒方式。
“有些防紫外线物品比如太阳伞,紫外光线难以穿透,也不适合用紫外线消毒。还有堆叠起来的衣服,消毒这类产品需要保证污染面都能够照射到紫外线,堆叠织物其实只有表面的衣服有良好消毒效果。”
【注意】
在产品规定的照射时长内
光照时间越长消毒效果越好
在使用维护上,部分消毒包商家的网页宣称“可拆卸、可水洗”。那么水洗会否影响使用效果?叶汉翔表示,在安全的角度来说,是不建议这样设计的。因为拆卸下来的部分如果没有安装好的话,很容易造成紫外线泄露。所以设计的时候要注意,产品在没有安装好之前,是不能工作的。
“满足这个要求的产品,把有电器连接的部分拆卸后,包体本身是可以水洗的。但要注意在包洗干净后,一定要晾干才能安装使用。安装的时候一定要安装到位,以免产生泄露。”

叶汉翔介绍清洗维护的注意事项
消毒包日常使用还有哪些注意事项?叶汉翔介绍,需要注意所有的消毒包都有消毒时间,在消毒完成前,不要打断消毒过程。“比如在消毒时打开消毒包,增加消毒物品,这样整个消毒过程就需要重新来一次。在产品设置的照射时长范围内,消毒效果与时间有关,光照时间越长效果越好,但要注意塑料、硅胶等产品不要长期照射紫外线。”
【延伸】
消毒剂属于化学消毒
消毒包是利用紫外线和臭氧来杀灭病毒,属于物理消毒方式。主要适用于物体表面的消毒,通常距离不能太远,且强度需要满足要求,使用时人和宠物都需要远离,避免对人眼和皮肤造成损害。同时有些紫外消毒器会产生臭氧,一定要注意使用时环境通风良好。

SGS化妆品及日化产品实验室技术经理李继超介绍消毒剂产品
目前大众普遍使用的消毒剂,则属于化学方式,利用有机溶剂直接变性蛋白质并破坏病原体结构,或者是利用杀菌剂的强氧化性无差别杀灭。据SGS化妆品及日化产品实验室技术经理李继超介绍,市面上也出现一种雾化消毒器,就是采用超声波雾化器,把消毒液雾化后喷射到消毒空间,这类产品的优点是喷洒范围大、作业时间短,但其只是一种使用方式,重点应关注具体使用的消毒剂是什么。
“常见的有效成分包括含氯消毒剂、醇类消毒剂、季铵盐类消毒剂等。一些消毒剂如过氧化物类消毒剂、二氧化氯消毒剂等,前者因其放置中会发生化学变化,后者本身具有危险性,故居家日常生活中接触不多。”
出品:南都鉴定评测实验室
主持:陈养凯
策划/出镜:杨丽云
采写:南都记者 陈菁钰 杨丽云
摄影:南都记者 马强
直播:卫志凌 邓启祥
海报设计:张博
如果您有相关线索
欢迎发送邮件到
nandujianding@qq.com
也可通过微信/抖音
搜索“鉴定评测实验室”
与“鉴定君”随时互动
下一篇:没有了
-

- 康宁大猩猩第三代玻璃有何特点(细数三星与康宁大猩猩玻璃的不解之缘)
-
2026-01-25 23:42:27
-

- 2003年,男子遭同性性侵后连杀6人并将其全部阉割,被捕时很淡定
-
2026-01-25 23:40:12
-

- 中国城市|黑龙江—牡丹江
-
2026-01-25 23:37:58
-

- 被称苏联最蠢元帅,开会说话漏洞百出,专家却说:他是扮猪吃老虎
-
2026-01-25 23:35:44
-
- 2025中考作文押题预测及范文5篇,90%命中率,快背!
-
2026-01-25 23:33:29
-

- 《空洞骑士》攻略:泪水之城
-
2026-01-25 23:30:21
-

- 中国第一大毒枭被枪毙!还有人吹他“爱国英雄”?
-
2026-01-25 23:28:07
-

- 锚定优质均衡“小目标” 办好人民满意“大教育”——凤县创建全国义务教育优质
-
2026-01-25 23:25:53
-

- 许昌鄢陵:花木之乡如何把风景卖到全国丨河南经济地理⑪
-
2026-01-25 23:23:38
-

- p40上市时间(二手华为p40现在值多少钱)
-
2026-01-25 23:21:24
-

- 玫红色成为这一季的黑马,自带亮眼吸睛技术,春天穿太美了
-
2026-01-25 09:33:36
-

- 德云社师徒反目事件:曹云金大闹生日宴,郭德纲泪洒未央宫
-
2026-01-25 09:31:22
-

- 成都市武侯区领川外语学校(4位热血青年的办学奇迹)
-
2026-01-25 09:29:07
-

- 「最新」156人、20人!莆田市教育局公示两份名单!
-
2026-01-25 09:26:53
-
- 5.12汶川大地震9周年迄今为止最全组图,看完后已泪流满面!
-
2026-01-24 22:56:07
-

- 五位“帝都红三代”:军人世家、将门之后,各个都是人中龙凤
-
2026-01-24 22:53:52
-
- 常州汽车客运北站即将竣工,9月26日正式投运!
-
2026-01-22 17:26:23
-

- 标题:日本出云号航母——从战列舰到直升机驱逐舰的演变
-
2026-01-22 17:24:09
-

- 2022除夕接神时间怎么选?2022年除夕夜的日期
-
2026-01-22 17:21:55
-

- 以下7点,出现2点以上,是领导把你当心腹了!
-
2026-01-22 17:19:40



 古代女人为什么会肛裂死
古代女人为什么会肛裂死 怎样用棉绳把自己手反绑
怎样用棉绳把自己手反绑